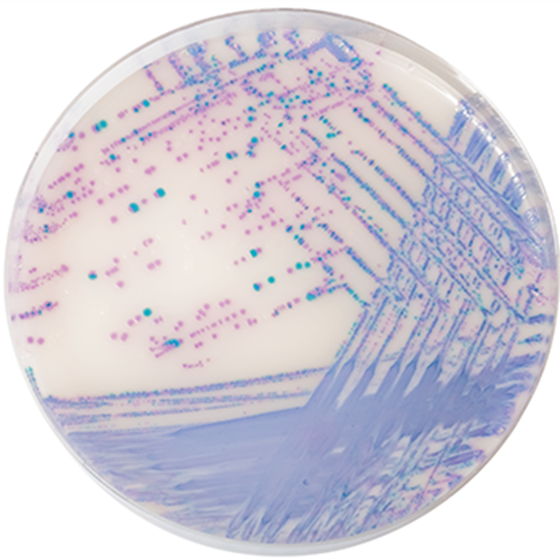

Über das Produkt
Chromogenes Medium zur Isolierung von Salmonellenarten, einschließlich S. typhi und Laktose-positiven Salmonellen nach ISO 6579-1.
Produkte
Mikrobiologie
CHROMagar™ - Trockennährmedien
CHROMagar Salmonella Plus (5L) ohne CE
CHROMagar Salmonella Plus (5L) ohne CE
Chromogenes Medium zur Isolierung von Salmonellenarten, einschließlich S. typhi und Laktose-positiven Salmonellen nach ISO 6579-1.